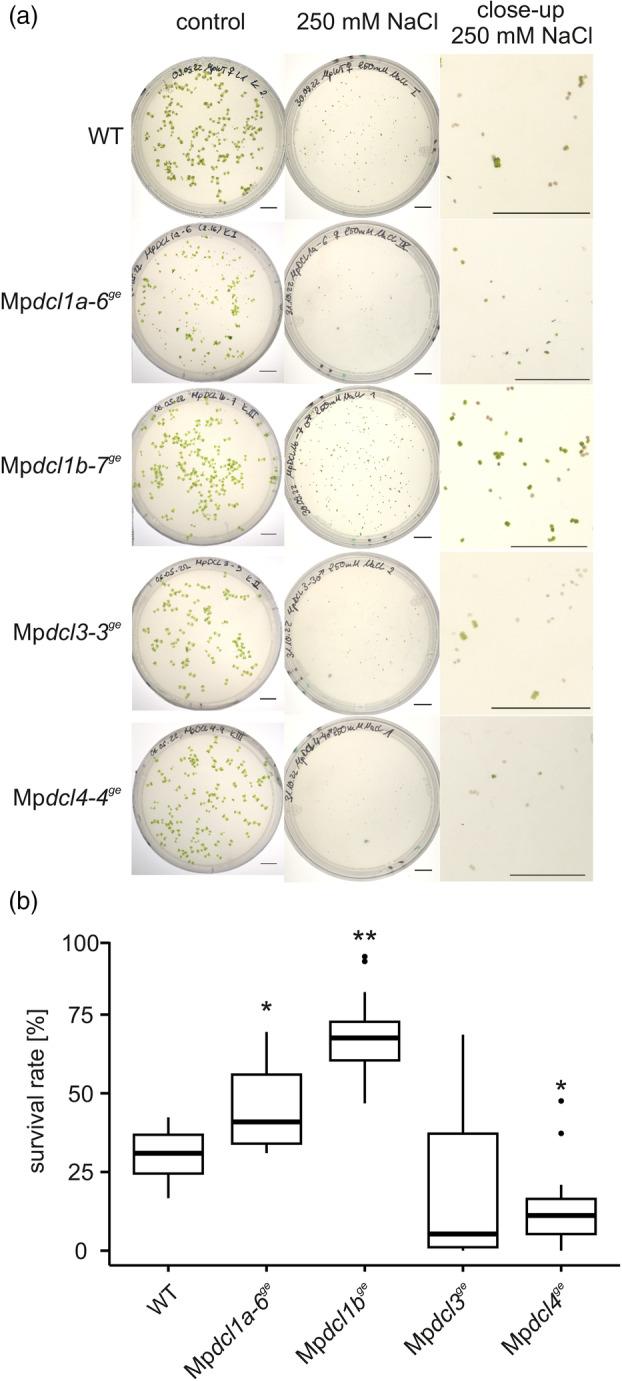
https://cdn.ncbi.nlm.nih.gov/pmc/blobs/2c8d/11799827/ad5e86ea91d7/TPJ-121-0-g006.jpg

Dicer样基因的鉴定与表征及其在多歧苏铁发育和盐胁迫响应中的作用。 (注:你原文中的Marchantia polymorpha是多歧苏铁,可能存在错误,一般常见的是Marchantia polymorpha指地钱,但按照你提供的原文准确翻译就是上述内容)
Identification and characterization of DICER-LIKE genes and their roles in Marchantia polymorpha development and salt stress response.
作者信息
Csicsely Erika, Oberender Anja, Georgiadou Anastasia-Styliani, Alz Johanna, Kiel Sebastian, Gutsche Nora, Zachgo Sabine, Grünert Jennifer, Klingl Andreas, Top Oguz, Frank Wolfgang
机构信息
Plant Molecular Cell Biology, Faculty of Biology, Ludwig-Maximilians-Universität München, LMU Biocenter, Großhaderner Str. 2-4, Planegg-Martinsried, 82152, Germany.
Division of Botany, School of Biology/Chemistry, Osnabrück University, Barbarastrasse 11, Osnabrück, 49076, Germany.
出版信息
Plant J. 2025 Feb;121(3):e17236. doi: 10.1111/tpj.17236.
DICER-LIKE (DCL) proteins play a central role in plant small RNA (sRNA) biogenesis. The genome of the early land plant Marchantia polymorpha encodes four DCL proteins: MpDCL1a, MpDCL1b, MpDCL3, and MpDCL4. While MpDCL1a, MpDCL3 and MpDCL4 show high similarities to their orthologs in Physcomitrium patens and Arabidopsis thaliana, MpDCL1b shares only a limited homology with PpDCL1b, but it is very similar, in terms of functional domains, to orthologs in other moss and fern species. We generated Mpdcl mutant lines for all MpDCL genes with the CRISPR/Cas9 system and conducted phenotypic analyses under control, salt stress, and phytohormone treatments to uncover specific MpDCL functions. The mutants displayed severe developmental aberrations, altered responses to salt and phytohormones, and disturbed sexual organ development. By combining mRNA and sRNA analyses, we demonstrate that MpDCLs and their associated sRNAs play pivotal roles in regulating development, abiotic stress tolerance and phytohormone response in M. polymorpha. We identified MpDCL1a in microRNA biogenesis, MpDCL4 in trans-acting small interfering RNA generation, and MpDCL3 in the regulation of pathogen-related genes. Notably, salt sensitivity in M. polymorpha is dependent on MpDCL1b and Mpdcl1b mutants display enhanced tolerance and reduced miRNA expression in response to salt stress. We propose that M. polymorpha employs specific mechanisms for regulating MpDCL1b associated miRNAs under high salinity conditions, potentially shared with other species harboring MpDCL1b homologs.
类Dicer(DCL)蛋白在植物小RNA(sRNA)生物合成中起核心作用。早期陆地植物多歧苏铁的基因组编码四种DCL蛋白:MpDCL1a、MpDCL1b、MpDCL3和MpDCL4。虽然MpDCL1a、MpDCL3和MpDCL4与其在小立碗藓和拟南芥中的直系同源物具有高度相似性,但MpDCL1b与PpDCL1b仅具有有限的同源性,但其在功能域方面与其他苔藓和蕨类物种的直系同源物非常相似。我们利用CRISPR/Cas9系统为所有MpDCL基因生成了Mpdcl突变体株系,并在对照、盐胁迫和植物激素处理下进行了表型分析,以揭示特定的MpDCL功能。这些突变体表现出严重的发育异常、对盐和植物激素的反应改变以及性器官发育紊乱。通过结合mRNA和sRNA分析,我们证明MpDCL及其相关的sRNA在多歧苏铁的发育、非生物胁迫耐受性和植物激素反应调节中起关键作用。我们确定了MpDCL1a在微RNA生物合成中的作用、MpDCL4在反式作用小干扰RNA生成中的作用以及MpDCL3在病原体相关基因调节中的作用。值得注意的是,多歧苏铁的盐敏感性取决于MpDCL1b,Mpdcl1b突变体在盐胁迫下表现出增强的耐受性和降低的miRNA表达。我们提出,多歧苏铁在高盐条件下采用特定机制调节与MpDCL1b相关的miRNA,这可能与其他含有MpDCL1b同源物的物种共有。